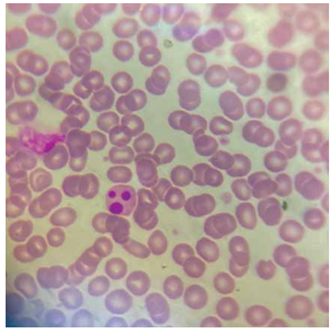
Enunciado 4571479-1

Em uma lâmina de sangue periférico, foram observados os elementos a seguir.

(Imagem gentilmente cedida pelo Laboratório de Análises Clínicas do Centro Universitário-FMABC)
A imagem indica a presença de
Provas
Questão presente nas seguintes provas
Em uma lâmina de sangue periférico, foram observados os elementos a seguir.
(Imagem gentilmente cedida pelo Laboratório de Análises Clínicas do Centro Universitário-FMABC)
A imagem indica a presença de